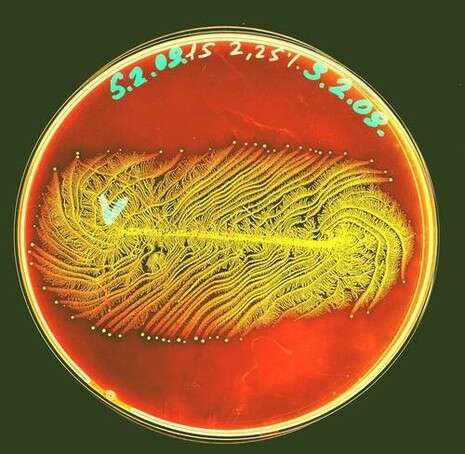

לא ייאמן: חיידקים יוצרים אמנות מרהיבה
תערוכה חדשה באוניברסיטת תל אביב תציג את היצורים הזעירים באופן צבעוני ומרתק. הרצאה במסגרת סדרת "אתנחתא" תאפשר למבקרים להבין טוב יותר את עולמו של החיידק, כיצד הוא גם מועיל לנו, ואת הקשר של מושבות החיידקים לידוענים ההוליוודיים
תערוכה חדשה העוסקת בחיידקים שתעלה באוניברסיטת תל אביב, תציג את הצד האחר והמרהיב של החיידקים. ניתן יהיה להכיר את עולמם המסתורי, כיצד הם עובדים בשיתוף פעולה הדדי בינם לבין עצמם ועד כמה הם חיוניים לחיינו. בתערוכה יוצגו צלחות פטרי המכילות חיידקים היוצרים מגוון צורות מרהיבות אודות לתקשורת ביניהם.החיידקים הינם יצורים חיים מיקרוסקופיים, אשר למרות שלא ניתן לראותם בעין בלתי מזוינת, השפעתם על החיים בכדור הארץ בכלל ועלינו, בני האדם, בפרט, היא אדירה.
לאור ההתפתחות הרבה שחלה בשנים האחרונות ביכולות הזיהוי שלנו, ובעיקר בפיתוח שיטות גנומיות חדשניות, ניתן להעריך ביתר קלות את מגוון החיידקים בטבע, את יכולותיהם, ואת השפעתם הישירה על חיינו. לא חולף יום ללא תגלית המצביעה על השפעת העולם המיקרוביאלי על חילוף החומרים בטבע, על איכות הסביבה ועל תהליכים גיאוכימיים, על היותם גורם מרכזי בשרשרת המזון וברפואה, על היותם גורמי מחלות לחי ולצומח ועל דרכי מניעתם, וכן היותם של חיידקים כפלטפורמה ליישומים ביוטכנולוגיים המיועדים לתועלת האדם.

חיידקים יוצרים אמנות
אשל בן יעקב
בהרצאה הראשונה בסדרת "אתנחתא" באוניברסטית תל אביב, יסופר על מדע המיקרוביולוגיה, על הבעיות, ההתמודדות ועל החשיבות של החיידקים השונים על עולמנו, בשילוב ממצאים מרתקים ודוגמאות מרהיבות של חיידקים צבועים. הצבעים שנוספו ליצורים השקופים, בדרך כלל, יוצרים תמונות מהפנטות של היצורים המזעריים שיוצגו בתערוכה החל מיום ראשון הקרוב.
התערוכה נולדה בהמשך למחקרים של אשל בן יעקב המתעניין לא רק בגנום של החיידקים שהוא חוקר אלא גם בחיי החברה שלהם. הוא משווה רבים מהם, היוצרים מושבות בצורות משובבות עין, לידוענים בהוליווד. "מצד אחד, אנחנו מעריצים אותם משום יופי המבנים שהם יוצרים, אבל מצד שני אנחנו סבורים שהם טיפשים", אומר בן יעקב, פרופסור לפיזיקה באוניברסיטת תל אביב.
עוד כותרות ב-nrg:
מגבעת חלפון עד אסקימו לימון: כל מה שהכי ישראלי
מתחביב למותג: לירן חולצה אפורה כבר טאלנט
המתח והפשרה בין האתוס הציוני לעולם התורה
כל התכנים הכי מעניינים - בעמוד הפייסבוק שלנו
הסימטריה של הבקטריה
אשל בן יעקב

חיידק פסיכודאלי
אשל בן יעקב

גשם סגול
אשל בן יעקב

תקשורת בין חיידקית
אשל בן יעקב

חיידקים מתקשרים
אשל בן יעקב

צילום אמנותי של צלחת פטרי
אשל בן יעקב

החיידקים של ואן גוך
אשל בן יעקב
המפגשים יתקיימו אחת לחודש באודיטוריום סמולרש בקמפוס האוניברסיטה, בין השעות: 18:00 - 22:30.
רשימת המפגשים בסדרה לשנת 2014-2015 כוללת:
26 אוקטובר - עולם של חיידקים
26 נובמבר - נפלאות התבונה
30 דצמבר - ילדים וילדות
28 ינואר - תחזית ונבואה
19 מרץ - המזרח הרחוק
28 אפריל - מזון
19 מאי - סביבה חכמה
14 יוני - אלוהים
היכנסו לעמוד הפייסבוק החדש של nrg

 נא להמתין לטעינת התגובות
נא להמתין לטעינת התגובות